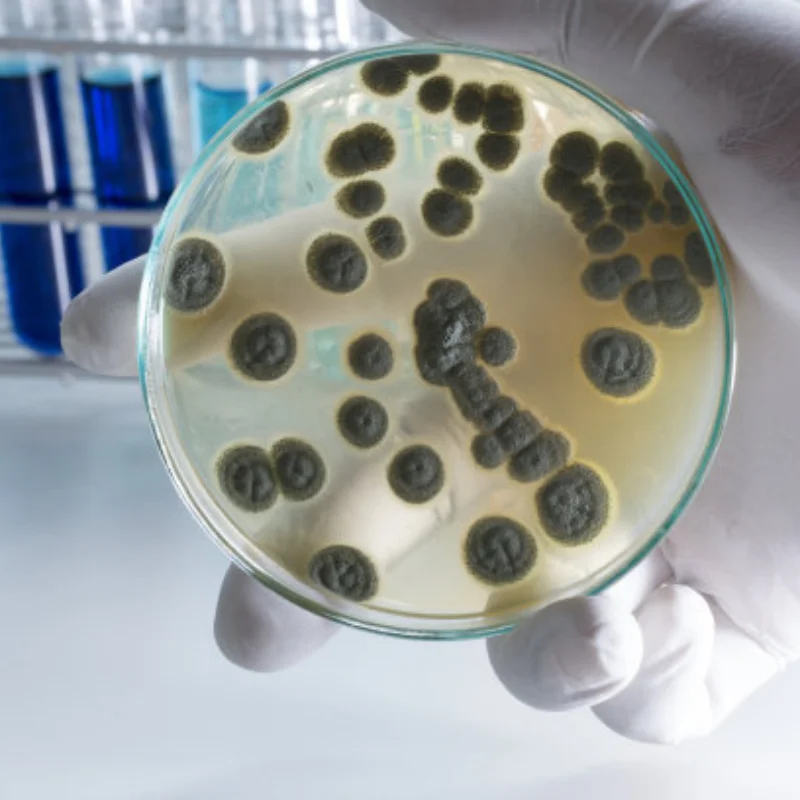
4Pcs Set High Grip Hot Melt Tyres 25°30°35°40°45° Wheel 65*25mm for 1/10 Scale RC Racing Cars Upgrade Parts

Милый медведь, пузатая чашка для питья, 1000 мл, большая емкость, прозрачная пластиковая соломенная чашка для воды для девочек, портативный кубок для воды на открытом воздухе с ремешком 1000ml розовый
График изменения цены & курс обмена валют
Пользователи также просматривали

6,561.89 руб.
6 ~ 8-уровневая полка для обуви Tower Spinning Lazy Susan, вращающаяся карусель, сумка для хранения, дисплей, организованная обувь, компактное пространство, вертикальное
aliexpress.ru
1,290.99 руб.
New Shelves Closet Wardrobe Organizers Storage Shelves Racks Telescopic Shelves Wall Mounted Racks for Kitchen Accessories
aliexpress.com
27,810.86 руб.
Настольный компьютерный стол для спальни, дома с выдвижным ящиком, студенческий письменный учебный стол, современная офисная мебель, многофункциональный игровой стол
aliexpress.ru
10,711.71 руб.
Облегающие блестящие платья средней длины с имбирными бриллиантами, весна-лето 2023, высокое качество, новинка для женщин
aliexpress.ru
984.55 руб.
MUSTOOL 2 In 1 1500W Cordless Electric Air Blower Vacuum Blowing Suction Leaf PC Dust Cleaner Collector For Makita 18V Battery
aliexpress.ru
875.32 руб.
Тактическая многофункциональная сумка для охотничьей винтовки, сумка для магазина, бандалайер, подставка для щек, подставка, карман для боеприпасов Mag
aliexpress.ru
3,520.26 руб.
Bleach: Thousand Year Blood War Yhwach Cosplay Costume Outfits Halloween Carnival Suit Role Play
aliexpress.com
1,592.88 руб.
Мотоциклетное зеркало заднего вида CNC, алюминиевые боковые зеркала WR250 для YAMAHA WR125 X R WR 250 1994 1995 1996 WR250R WR250X
aliexpress.com
3,026.46 руб.
Макетная плата модуля CCD линейного массива, функция небольшого объема и низкой стоимости, мощный последовательный порт или выход USB TCD1304
aliexpress.ru
185.84 руб.
Carbon Steel Left Right Wings Slot Adjustable Durable Cycling Bike Bicycle Rear Derailleur Chain Stay Guard Gear Protector
aliexpress.com
7,000.31 руб.
Chest bags waist bag P necessitie s space to meet the necessities of daily life lightweight waterproof fabric2532918, Black
dhgate.com
10,415.89 руб.
Air 1 High OG Court Purple Black White 555088-501 1s I Women Men Sports Casual Shoes Sneakers Sneaker Top Quality Trainers Kicks With Origin, Red thunder
dhgate.com
379.26 руб.
Kitchen household 6L capacity electric pressure cooker electric pressure cooker authentic rice cooker
alibaba.com
4,285.59 руб.
men's jeans 2021 summer autumn thin dropping straight wide leg harem loose mop ins casual fashion brand hip hop pants, Blue
dhgate.com
1,371.39 руб.
women's jumpsuits & rompers women casual sleeveless v neck backless floral romper jumpsuit club bodysuit playsuits pants summer clothes, Black;white
dhgate.com
3,265.45 руб.
carpets 12 style floral print anti-slip floor mat outdoor rugs front door mats 40x60 50x80cm.
dhgate.com
1,581.50 руб.
bathroom storage & organization portable travel jewelry box organizer velvet jewellery ornaments case earring ring necklace luxury display
dhgate.com
1,198.45 руб.
pudcoco girl dress lovely baby girls short sleeve toddler kids casual summer sundress clothes, White
dhgate.com
1,765.34 руб.
summer vacation 25cm along the beach sun hat beach hat women's foldable, Black;white
dhgate.com
3,539.98 руб.
portable game players 4.3'' video console retro handheld pocket 2000 games player classic feelings favorite
dhgate.com
7,803.57 руб.
dress shoes meotina high heels women pumps glitter platform thick buckle round toe party ladies spring big size 33-42, Black
dhgate.com
2,702.58 руб.
Men's Bomber Jacket Military Tactical Jacket Outdoor Quick Dry Lightweight Breathable Sweat wicking Jacket Top Fishing Climbing Running ArmyGreen Black khaki
lightinthebox.com
711.48 руб.
Летние футболки с принтом Y2k Avril Lavigne Funny He was a boy, мужские и женские милые футболки большого размера с короткими рукавами, топы унисекс из 100% хлопка
aliexpress.ru
17,465.84 руб.
Ростела Танго 3+ 1" боковое правое подключение 50x100 см, Танго 3+ 1" боковое правое подключение 50x100 см
amd.by
978.48 руб.
4Pcs Set High Grip Hot Melt Tyres 25°30°35°40°45° Wheel 65*25mm for 1/10 Scale RC Racing Cars Upgrade Parts
aliexpress.ru
339.06 руб.
For Suzuki GSR750 GSR 750 2011 2012 2013 2014 2015 2016-2025 Motorcycle Adjustable Clutch Brake Levers Handle Bar End Grips Caps
aliexpress.ru








